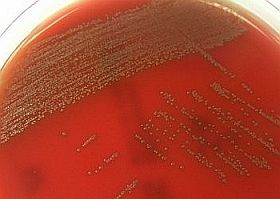
Gyökeresen átalakulhat a betegségekről alkotott képünk!

Képzeljünk el egy több milliárd mikroszkópikus élőlényből álló életközösséget, melyben egymással versengő és együttműködő fajok élnek hihetetlen változatosságban. Ami pedig igazán érdekessé teszi az egészet; mindez a testünkben található. Mikróbák élnek a bőrünk felszínén, a testhajlatainkban, a szánkban és a bélcsatornában. A felfedezés nem új keletű azonban ennek a hihetetlenül összetett rendszernek az orvosi – egészségügyi jelentőségét csak mostanában kezdjük felfedezni.
Biológusok egyre növekvő csoportja tekint az emberre nem csupán a megtermékenyítés pillanatában egyesülő petesejt és hímivarsejt leszármazottjaként, hanem egy összetett rendszer részeként. Kivétel nélkül mindannyian ugyanis több trillió más élőlénnyel élünk szoros közösségben.

Gyökeresen átalakulhat a betegségekről alkotott képünk!
Forrás: MTI
Becslések szerint a testünkben 10-szer annyi mikróba él, mint amennyi a sejtjeink száma. Sőt, ezek többé – kevésbé különböznek egymástól. Testünk sejtjei kb. 23.000 gént hordoznak, melyeket mind a szüleinktől örököltünk.
Ezzel szemben a bakteriális eredetű, vagyis társbérlőink génjeinek száma 3 millió. Kétségtelen, hogy nagyrészük ugyanazon tulajdonságok kialakításáért felelős, vagyis variáció egy témára. Nem elhanyagolható viszont azon gének száma, amik nem ebbe a kategóriába tartoznak és a "rendszer" genetikai összetettségét növelik.
A mikrobióta
Az ember a testében élő baktériumokkal (összefoglalóan ezt a baktérium közösséget mikrobiótának nevezzük) valóban együtt képez egy szerves egészet. Ez a kötelék az együtt fejlődés, egymáshoz igazodás (koevolúció) évezredes folyamatának eredményeként jött létre. Az együttélés kölcsönös előnyökre épül, a nyersanyagért és a védett élőhelyért cserébe a bennünk élő baktériumok fontos tápanyagokkal látnak el minket emellett egészségvédő szerepük is van, vagyis hozzájárulnak a gazdaszervezet általános jóllétéhez. Az egyensúly azonban törékeny, előfordulhat, hogy valamilyen hatásra az addig hasznos vagy legalábbis ártalmatlan mikrobák ellenünk fordulnak és megbetegítenek.
A baktériumok betegségeket okozhatnak – ez persze senkinek sem újdonság. Ami meglepő az a szóban forgó betegségek sora. Nem az akut fertőzésekről van szó, amiket a modern orvostudomány újabb és újabb gyógyszerekkel viszonylag sikeresen kezel (tekintsünk most el az antibiotikumokkal szembeni rezisztencia cseppet sem elhanyagolható problémájától). Hatékony fegyvertár áll rendelkezésünkre a baktériumok kiirtására, miközben a bennünk élő fajokról és ezek szerepéről igen keveset tudunk. A fejlett országok lakosait jellemző krónikus betegségek - elhízás, cukorbetegség, szívbetegségek, asztma, szklerózis multiplex és más neurológiai/pszichés betegségek mint például az autizmus - esetében a mikróbák szerepe lényegesen nagyobb, mint eddig bárki gondolta volna.
Milyen a baktérium élete?
Az emberi baktériumflóra felfogható akár önálló szervként is. Tömege 1 kg körüli több más szervünkhöz hasonlóan. Ugyan nem "megfogható", mint a szív vagy a vese, hanem az immunrendszer testszerte elszórt sejtjeihez hasonlatos, melyek szintén nem formálnak egy körülhatárolható szervet.
Jelen állás szerint a baktériumoknak 100 nagy csoportja különíthető el és mindegyik más-más biokémiai kapacitással rendelkezik. Az ember bélrendszerében ebből négy csoport képviseltetni magát, ezek az Actinobacteria, Bacteroidetes, Firmicutes és Proteobacteria fajok.
Földrajzi egységenként a táj képéhez hasonlóan az emberekben élő baktériumok is eltérő mintázatot mutatnak. Egy Malawiban vagy Venezuelában élő kisgyermek bélrendszerében például észak-amerikai vagy európai társaikhoz képest jóval több riboflavint előállító baktérium él. Emellett az anyatejben található tápanyagok hasznosítása szintén hatékonyabb az ő esetükben. Több glikozid hidroláz nevű enzim áll rendelkezésükre ugyanis a glikánok (a tejben található bizonyos típusú szénhidrátok) a szervezet számára hasznosítható cukorrá alakításához.
Az enzimet kódoló gének viszont nem találhatók meg a humán genomban, azt kizárólag a baktériumok képesek előállítani. A tej pedig bővelkedik ezekben a szénhidrátokban. Gyönyörűen példázza ez a koevolúció működési mechanizmusát.
A mikrobák a későbbi életszakaszokban is fontos szerepet töltenek be a táplálkozásukban. Számos összetett szénhidrát lebontására és hasznosítására nem lennénk képesek, ha csak a saját génállományunkra és az általuk kódolt enzimekre hagyatkozhatnánk. Egy átlagos felnőtt által felhasznált energia 10-15%-át a bakteriális lebontásból származó és felszívódó molekulák adják.
Gyökeresen átalakulhat a betegségekről alkotott képünk!
Forrás: MTI
Elhízás és alultápláltság
A mikróbák tápanyagok lebontásában való közreműködését átlátva, felvetődött a kérdés a tudósokban. Lehet-e szerepük a hiánybetegségek kialakulásában vagy akár az elhízásban? Egy 2006-os amerikai tanulmányban normál testtömegű és túlsúlyos egyének bélrendszerében élő baktérium közösség összetételét vizsgálták. Utóbbiaknál a Firmicutes csoport tagjai nagyobb számban voltak jelen és kevesebb volt Bacteroidetes csoport képviselőiből, mint a vékony egyéneknél. Érdekes még, hogy akik megszabadultak a túlsúlyuktól azoknál a baktérium közösség összetétele is eltolódott a vékonyabbakra jellemző felé.
Egereken végzett kísérletek eredményei alapján itt nem pusztán a megváltozott környezethez történő alkalmazkodásról van szó. A zsír tárolását és energiaként történő felszabadítását szabályozó hormonok előállításának befolyásolásán keresztül mutatkozik meg a baktériumok szerepe a testtömeg alakulásában. Ez lehet a magyarázata az állattenyésztőknél régóta ismert különös jelenségnek, miszerint a borjúk hízása gyorsabb ütemben zajlik, ha antibiotikumot kevernek a tápba.
Miután kimutatták a bélben élő baktériumok és az elhízás közti egyértelmű összefüggést, ennek ellenkezője is bebizonyosodott. Malawi gyerekek bevonásával végzett vizsgálat kimutatta, hogy a nem megfelelő összetételű mikrobióta alultápláltsághoz vezet.
A végső bizonyítékot ebben az esetben az ikervizsgálatok különös eredményei adták. A feltehetően hasonló módon táplálkozó párok felénél az egyik tag megfelelően- míg a másik alultáplált volt. A fentiek ismeretében nem meglepő, hogy az ilyen párosok mikrobiótája igencsak különbözött egymástól. Az alultápláltak esetében a vitaminszintézis és bizonyos komplex szénhidrátok lebontása is gátolt volt. Mikor kísérleti jelleggel a mikróbákat átültették steril bélrendszerrel rendelkező laboratóriumi egerekbe, azok tápláltsági állapota a donorokéhoz hasonlóvá vált. Ezek után valószínűsíthető, hogy az alultápláltság megfelelő mennyiségi és minőségi táplálkozás mellett is előfordulhat pontosan az egyén bélrendszerében élő baktérium közösség összetétele miatt.
A bélben élő baktériumok és a táplálkozás összefüggése talán magától értetődőnek tűnik. A cukorbetegség, a szívbetegségek vagy a szklerózis multiplex esetében már nem ennyire nyilvánvaló az összefüggés.
Szívbetegségek
A szívbetegségekkel kapcsolatban egerekkel végzett és humán vizsgálati eredmények egyaránt rendelkezésünkre állnak. Az anyagcsere termékek és a betegségek kapcsolatának vizsgálatakor azt találták, hogy az alanyok vizeletéből kimutatható hangyasav fordított arányban áll a vérnyomás értékével, amely pedig a szívbetegségek rizikójának egyik mutatója. A kettő közti kapcsolatot feltehetően a hangyasav veseműködésre gyakorolt hatása jelenti. Mivel a hangyasav elsődleges forrását a baktériumok jelentik, jogos a felvetés, hogy a bélrendszerünkben élő mikróbák a vérnyomásunkra is hatással vannak.
Az egereken végzett vizsgálatok pedig a szív-és érrendszeri megbetegedések kialakulásának másik lehetséges mechanizmusát mutatták. Olyan egereket tenyésztettek, melyeknek fokozott hajlama volt az artériák rugalmatlanná válására. Ezeknél a bélflóra antibiotikumokkal történő megsemmisítése szignifikánsan csökkentette az érelmeszesedés előfordulását, bár ennek oka még nem tisztázott.
2-es típusú cukorbetegség
Hasonlóan tisztázásra vár még a baktériumok 2-es típusú diabétesz kialakulásában játszott szerepe. Kórosan elhízott egyéneknél testtömeg csökkentés céljából időnként úgynevezett gyomor-bypass műtétet végeznek. Az eljárás során a gyomor és a vékonybél egy szakaszát kiiktatják, így kevesebb lesz az elfogyasztott táplálék és abból kisebb mennyiség tud felszívódni. A páciensek a túlsúly mellett szinte mindig diabéteszben is szenvednek. Az elhízás igen eredményesen kezelhető az eljárással, ami viszont meglepő, hogy a betegek 80%-ánál a beavatkozást követően néhány nappal megszűnt a diabétesz. A műtét kimutatható változást okoz a bélflóra összetételében, feltételezések szerint ez vezet az állapot javulásához.
A 2-es típusú diabétesz oka a sejtek érzékenységének csökkenése vagy teljes megszűnése a vércukorszint szabályozását irányító egyik hormonra, az inzulinra. Az inzulin érzékenység egy összetett és máig nem egészen tisztázott molekuláris jelátviteli folyamat. Azt gyanítják, hogy ezen szabályozási lánc részét képezik a bélflóra baktériumai is.

Gyökeresen átalakulhat a betegségekről alkotott képünk!
Forrás: MTI
Autoimmun betegségek
Az autoimmun betegségek terén (amikor védekező rendszerünk a szervezet saját egészséges sejtjeire támad) szintén gyanítható a baktériumok közreműködése. A bélfalában az immunrendszer számos sejtje található meg. Feladatuk a potenciálisan veszélyes baktériumok azonosítása, ezt a sejtfelszíni jelzőmolekulák alapján képesek megtenni. Néha az immunsejtek összekeverik a káros baktériumok és a szervezet saját sejeinek felszínén lévő molekulákat és ez utóbbiakra támadnak. Itt sem tisztázott, hogy ez csupán a rossz szerencse, vagy itt is a mikrobióta összetételének eltérése ütközik ki.
Kutatók szerint hasonló autoimmun mechanizmus állhat az 1-es típusú diabétesz (az inzulint előállító sejtek autoimmun eredetű pusztítása okozza) asztma, ekcéma és szklerózis-multiplex hátterében. A részletek nem tisztázottak, de feltételezhető a mikrobióta bizonyos összetevőinek szerepe. Ezek megtévesztik az immunrendszert, aminek a szervezet saját sejtjei látják a kárát.
Szklerózis-multiplex esetében egy nemrég publikált tanulmány egereken igazolta a bélbaktériumok szerepét az immunrendszer kóros működésében. A folyamat eredményeként saját védekezőrendszerünk bontja le az idegsejtek megfelelő működéséhez elengedhetetlen szigetelő hüvelyt.
A fenti példák azonban felvetnek egy újabb kérdést. Ha bélbaktériumok megbetegíthetnek, akkor azok kiirtásával még a mai tudásunk szerint gyógyíthatatlan betegségekből is felépülhetünk? A joghurtgyártók ezt már évek óta hangoztatják. Segítsük a hasznos bélbaktériumok elszaporodását! Logikusnak tűnik, hogy ha a megfelelő baktériumokat juttatunk külső forrásból szervezetünkbe, az egészségi állapotunk jelentősen feljavul.
Kultúrák ütközése
Klinikai vizsgálatok eredményei valóban arra utaltak, hogy a probiotikumok (hasznos baktériumok, melyek megtalálhatóak például a joghurtban) enyhíthetnek az IBS (irritábilis bél szindróma) tünetein. A betegek bélflóráját vizsgálva az gyakran a normálistól enyhén eltérőnek mutatkozik. Kérdéses azonban, hogy ez a jótékony hatás jelentkezik-e egészséges egyéneknél is.
A tavalyi évben érdekes tanulmányt publikáltak a témában. Egészséges egypetéjű ikrek vizsgálatakor azt találták, hogy a joghurt fogyasztás nem volt hatással a mikrobióta összetételére. A pár egyik tagja hónapokon át rendszeresen fogyasztott joghurtot, de semmilyen változás nem volt kimutatható.
A joghurt fogyasztásával csak kevés fajta baktériumot vagyunk képesek bejuttatni a szervezetbe. Létezik azonban olyan mechanizmus, amellyel egész bakteriális közösségek vihetők át egyik bélrendszerből a másikba. Az eljárás az első hallásra igen elrettentőnek tűnő széklet transzplantáció. A beavatkozás lényegében az, aminek hangzik; egészséges donorból származó székletdarabot fiziológiás sóoldatban szuszpendálva beöntéssel a beteg vastagbelébe juttatják.
Kísérleti jelleggel az Egyesült Államok néhány kórházában már alkalmazzák az eljárást Clostridium difficile okozta fertőzés kezelésére. A baktérium súlyos hasmenéssel és egyéb tünetekkel járó fertőzést okoz, döntően kórházban fekvő betegeknél. A fertőzés komolyságára utal, hogy egyedül az Államokban 14.000 ember halálát okozza évente. Ennek oka a C. difficile törzsek nagyfokú rezisztenciája a legtöbb antibiotikummal szemben. Ez megköveteli az olyan "nagyágyúk" bevetését, mint a vancomycin vagy a metronidazol, melyek sajnos általában válogatás nélkül kiirtják a beteg bélflórájának nagy részét. Ha ez megtörténik a C.difficile baktérium teljes eltüntetése nélkül, azt a baktérium megbosszulja.
A fertőzés által érintett betegek széklet transzplantációval történő kezelése meglepően jó eredménnyel jár. Az ilyen módon bejuttatott baktériumok rendkívül gyors szaporodásnak indulnak, betelítik a bél alsó szakaszát és "elűzik" a C. difficile-t. A beavatkozást 77 páciensnél végezték el, a siker pedig 91%-os volt. A nem reagáló betegnél a beavatkozás megismétlése az esetek döntő többségében sikert hozott. Ahhoz, hogy ez kezelés általános gyakorlattá váljon a hatékonyságát standardizált klinikai vizsgálatokkal kell igazolni. Az eddigi eredmények mindenesetre bizakodásra adnak okot egy igen súlyos probléma olcsó és hatékony megoldására.
Idegrendszeri ill. pszichés zavarok
Talán a legérdekesebb kérdés a mikrobióta és az idegrendszer kapcsolata. Régóta ismert, hogy az autisták bélrendszeri problémákkal is küzdenek és ez gyakran abnormális baktériumflórával párosul. Pontosan a bélrendszerükben nagy számban képviseltetik magukat a Clostridium fajok, ami döntő szerepet játszhat az állapot kialakulásában.
Minden ökoszisztémát versengés jellemez, még ha az stabil és produktív is, az emberi bélflóra sem mentes a "belső harcoktól". Az élőhelyért és tápanyagért folytatott versengés során a Clostridium fajok fegyvere a mérgező fenolok vegyületek (szerves vegyületek, egyes fertőtlenítő szerek összetevői). Ezek azonban az emberi sejtek számára is mérgek, ezért a szervezet, hogy semlegesítse őket, ként kapcsol hozzájuk. A baktériumok elszaporodása következtében felhalmozódó fenolok semlegesítése tehát a szervezet kén tartalékainak kimerüléséhez vezet. A kén azonban számos élettani folyamatban elengedhetetlen, ilyen többek között az idegrendszer fejlődése. A szokatlan összetételű mikrobióta tehát súlyos árat követel, amit az agy fizet meg.
Egyelőre nem bizonyított, hogy ez a mechanizmus lenne az autizmus kiváltó oka. Ismert azonban, hogy sok autista beteg a kén anyagcserét érintő zavarban szenved. A bélrendszerükben elszaporodó Clostridiumok pedig úgy tűnik tovább rontják a helyzetet.
A mikróbák tanulmányozása jelentősen egyszerűbbé vált az új DNS-szekvenáló technológiák megjelenésével. Nem szükséges őket Petri-csészékben kitenyészteni ami olykor hosszadalmas vagy komoly nehézségeket okoz. A tudományos életben eléggé előtérbe került ez a terület. A hasznos ismereteink bővülése mellet, ennek veszélyei is vannak. Az ezidáig hanyagolt mikróbáink előtérbe kerülése az eddigi eredmények félreértelmezését okozhatják.
Ez igaz-e vagy sem, nem kétséges a mikrobióta táplál minket, fenntartja az anyagcsere megfelelő működését, és néhány vagy esetleg számos módon árthatnak nekünk. És még egy dolog, generációkat köt össze, méghozzá olyan módon amire korábban nem is gondoltunk.

Gyökeresen átalakulhat a betegségekről alkotott képünk!
Forrás: MTI
Szülői örökség?
Számos kórkép létezik, amely újra és újra felbukkan egy családon belül, ezeket örökletes vagy genetikai eredetű betegségként emlegetjük. Az ilyen betegségek nem mindegyikénél tisztázott még a genetikai háttér. Ennek oka lehet egyrészt több gén együttes szerepe az állapot megjelenésében. Vagy talán nem is jó helyen keresik a felelős géneket.
A testünk mikrobiótáját ugyanis feltehetően szintén a szüleinktől örököljük, bár nem olyan egyértelmű módon, mint a génjeinket. Számos baktérium a szüléskor kerül be a bélcsatornánkba, és az édesanyánktól származik, vagy nem sokkal az után "költöznek belénk" a közvetlen környezetből. Elképzelhető tehát egyes öröklődő betegségek oka valójában a baktériumok továbbadása.
...és a jövő?
Mindez nem csupán érdekes tudományos felfedezés. Az ismert genetikai eredetű betegségek kezelése gyakran nehézkes, véglegesen nem gyógyíthatók és általában élethosszig tartó gyógyszerszedést igényelnek. A mikrobióta összetétele azonban az emberi genomtól eltérően módosítható gyógyszerekkel.
A fent említett példák csak ízelítőt jelentenek a közelmúlt izgalmas tudományos eredményeiből. Ha a mikrobióta szerepe beigazolódik egyes betegségek esetén, akkor az alapjaiban változtathatja meg az orvoslás gyakorlatát.
Forrás: economist.com
Kövesse az Egészségkalauz cikkeit a Google Hírek-ben, a Facebook-on, az Instagramon vagy a X-en,Tiktok-on is!








